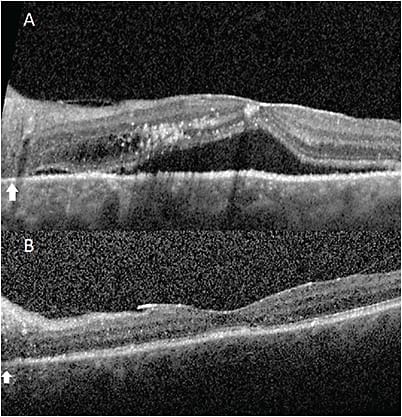
FIGURE 2: Heidelberg optical coherence tomography (OCT) of the left eye before surgery showing subretinal and intraretinal fluid (A) and two months after surgery (B) showing scleral windows. Arrow indicates temporal crescent with above intraretinal edema. IMAGE COURTESY ALBERT LIN, MD

Idiopathic uveal effusion syndrome (UES) clinically presents with ciliochoroidal effusions that appear dome-shaped with brown-orange elevation in the periphery.1 Posterior uveal effusion syndrome (PUES), a variant of idiopathic UES, presents primarily with a serous retinal detachment affecting the posterior pole. Uveal effusion syndrome is more common in eyes with shorter axial lengths or nanophthalmos (type 1); however, it has been reported in eyes with normal axial lengths as well (types 2 and 3).2 We report an unusual presentation of posterior uveal effusion syndrome in a non-nanophthalmic eye in the postoperative period following an uncomplicated cataract surgery.
CASE
A 68-year-old White male was referred to the retina service for a serous macular detachment after cataract surgery in the left eye. Preoperatively, his best corrected visual acuity (BCVA) was 20/200 due to a posterior subcapsular cataract. His phacoemulsification was complex due to a shallow anterior chamber requiring intravenous mannitol (21.35 mm axial length), but the surgery itself was uneventful. At postoperative month 1, BCVA was 20/200 with a +7.0 D hyperopic shift. Workup of his postoperative refractive surprise did not reveal any technical errors causing the refractive surprise—intraocular lens (IOL) power and placement were found to be correct.
Fundus exam (Figure 1a) of the left eye revealed a serous macular detachment involving the fovea with drusen and exudates, with 360° annular shallow ciliochoroidal detachments anterior to the equator seen on indirect ophthalmoscopy. B-scan ultrasonography confirmed these detachments, with less than 1 mm average height. Fundus autofluorescence (Figure 1b) of the left eye showed a hypofluorescent gravity track emanating from the nerve, with fluorescein angiography (Figure 1c) demonstrating similar findings with hyperfluorescence at the borders. Two additional foci of peripapillary stippled hyperfluorescence and temporal crescent staining were also noted on fluorescein angiography. Indocyanine green angiography (Figure 1d) was unremarkable. Optical coherence tomography (OCT) revealed a pigment epithelial detachment (PED) in the peripapillary retina with subretinal fluid involving the fovea and accompanying intraretinal fluid and exudates (Figure 2a). The choroid was also noted to be very thick with slight choroidal folds, and a temporal crescent with outer retinal atrophy was present in the peripapillary retina.

Tests for infectious etiologies, including syphilis and tuberculosis, were negative, and no inflammatory exam findings, such as anterior chamber cell and vitreous haze, were noted. Medical treatment with topical steroids and nonsteroidal anti-inflammatory drugs (NSAIDs), oral steroids, oral acetazolamide, and intravitreal bevacizumab (Avastin; Genentech) did not result in any significant improvement in vision or subretinal fluid. Focal laser of the PED failed to improve his condition.
After failing medical treatment, the patient elected to proceed with surgical intervention. Partial thickness scleral windows 5 mm x 5 mm wide with a sclerostomy were created in all four quadrants without complication. The sclera was noted to be abnormally thick during lamellar dissection, consistent with UES. No complications were noted postoperatively, and all subretinal fluid (Figure 2b) and ciliochoroidal effusions were resolved two months after surgery, with BCVA of 20/25.
CONCLUSIONS
The weeks to months following routine cataract surgery are usually uneventful but can have complications. While the most feared complication is acute postoperative endophthalmitis, cataract surgeons will more commonly encounter persistent postoperative inflammation, Irvine-Gass syndrome, or refractive surprises. Rarely, phacoemulsification can precipitate an occult inflammatory or infectious uveitis that was previously undiagnosed or a rhegmatogenous retinal detachment. The latter is more common if the surgery was complicated or had predisposing risk factors. In this case, phacoemulsification triggered the onset of this variant of uveal effusion syndrome.
In UES, typical clinical findings include peripheral choroidal effusions with shifting serous subretinal fluid. The pathophysiology of UES is hypothesized to be secondary to abnormal and disorganized scleral fibers impeding transscleral outflow of albumin, causing albumin to be concentrated in extravascular choroidal spaces. This in turn causes an osmotic gradient that pulls fluid towards the suprachoroidal space.3,4 In addition, abnormal scleral compression onto the vortex veins or increased resistance of venous outflow may impede outflow and result in choroidal fluid retention.5 These two mechanisms may work synergistically to cause the clinical findings noted in UES.
In PUES, the peripheral choroidal effusions may be absent, though in this case they were present but very shallow.6,7 Serous fluid instead enters the subretinal space to form a serous macular detachment. This process is hypothesized to occur due to pachychoroid hyperpermeability along with a weak point at the temporal crescent near the nerve that allows for choroidal fluid to extravasate into the subretinal space.7 This is supported by findings of gravity tracks seen on autofluorescence and fluorescein angiography around the nerve. Most eyes that develop PUES have peripapillary atrophy, which may provide such a channel for fluid to travel. Optical coherence tomography often reveals a pachychoroid macula which is consistent with choroidal thickening in UES and PUES.
Posterior uveal effusion syndrome, like EUS, is a diagnosis of exclusion. It can be mistaken for posterior uveitis because of its angiographic findings around the disc or other conditions that cause a serous retinal detachment, including central serous chorioretinopathy and Irvine-Gass syndrome.4,8,9 Cataract surgery has been found to potentially precipitate or exacerbate PUES, as in this case.7 The exact reason for precipitating PUES may be related to intraocular pressure fluctuations during surgery or postoperative inflammation, but it is still unknown. Multimodal imaging is extremely useful in ruling out some of the previously listed conditions and raising suspicion of PUES.
Though some limited evidence does show successful treatment of UES with medical therapy, the majority of the literature suggests that medical treatment is ineffective with long-term control. Photo-dynamic therapy may have some theoretical benefit due to its choroidal thinning effect but has not been studied. Definitive treatment of UES typically requires surgical management. Vortex vein decompression has been supplanted for lamellar sclerectomy to thin the sclera, with partial thickness scleral windows in all quadrants being one of the more common treatments. Clinically abnormal sclera (types 1 and 2) is typically the predictive factor for successful surgical outcomes.2 For PUES, the evidence is less clear, but case reports do describe PUES being successfully treated with carbonic anhydrase inhibitors and oral steroids for refractory cases that did not self-resolve.7,8 At the time of this writing, no PUES cases required surgical management for treatment. Our case, which could be categorized as a type 2 UES, was refractory to medical therapy, and only after lamellar sclerectomy did visual and anatomic improvement occur. NRP
REFERENCES
- Gass JD, Jallow S. Idiopathic serous detachment of the choroid, ciliary body, and retina (uveal effusion syndrome). Ophthalmology. 1982;89(9):1018-1032. doi:10.1016/s0161-6420(82)34685-0
- Uyama M, Takahashi K, Kozaki J, et al. Uveal effusion syndrome: clinical features, surgical treatment, histologic examination of the sclera, and pathophysiology. Ophthalmology. 2000;107(3):441-449. doi:10.1016/s0161-6420(99)00141-4
- Jackson TL, Hussain A, Salisbury J, Sherwood R, Sullivan PM, Marshall J. Transscleral albumin diffusion and suprachoroidal albumin concentration in uveal effusion syndrome. Retina. 2012;32(1):177-182. doi:10.1097/IAE.0b013e318218a95a
- Elagouz M, Stanescu-Segall D, Jackson TL. Uveal effusion syndrome. Surv Ophthalmol. 2010;55(2):134-145. doi:10.1016/j.survophthal.2009.05.003
- Gass JD. Uveal effusion syndrome: a new hypothesis concerning pathogenesis and technique of surgical treatment. Retina. 1983;3(3):159-163.
- Harada T, Machida S, Fujiwara T, Nishida Y, Kurosaka D. Choroidal findings in idiopathic uveal effusion syndrome. Clin Ophthalmol. 2011;5:1599-1601. doi:10.2147/OPTH.S26324
- Pautler SE, Browning DJ. Isolated posterior uveal effusion: expanding the spectrum of the uveal effusion syndrome. Clin Ophthalmol. 2014;9:43-49. doi:10.2147/OPTH.S75448
- Liu Q, Hemarat K, Kayser DL, Stewart JM. A case of posterior uveal effusion syndrome masquerading as uveitis. Retin Cases Brief Rep. 2017;11 Suppl 1:S124-S127. doi:10.1097/ICB.0000000000000463
- Maggio E, Polito A, Prigione G, Pertile G. Uveal effusion syndrome mimicking severe chronic posterior uveitis: a case series of seven eyes of four patients. Graefes Arch Clin Exp Ophthalmol. 2016;254(3):545-552. doi:10.1007/s00417-015-3176-y








